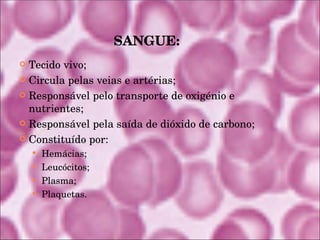
SANGUE: Tecido vivo; Circula pelas veias e artérias; Responsável pelo transporte de oxigénio e nutrientes; Responsável pela saída de dióxido de carbono; Constituído por: Hemácias; Leucócitos; Plasma; Plaquetas.

O documento resume o processo de transfusão de sangue, incluindo sua história, tipos sanguíneos, compatibilidade, doação e complicações. Aborda os objetivos da transfusão, os sistemas ABO e Rh para classificação sanguínea, a importância da doação voluntária e os cuidados necessários para doadores e receptores.